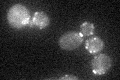
YPR171W
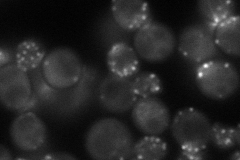
YPR171W
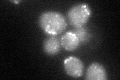
YPR171W
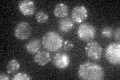
YPR171W

View description
Adapter that links synaptojanins Inp52p and Inp53p to the cortical actin cytoskeleton
Localization:
Intensity:
Fold change:
Significance:
-
C’ GFP library in SD
punctate28.37 -
N' NOP1pr-GFP in SD
punctate,bud64.768 -
N' TEF2pr-mCherry in SD

cell periphery,vacuole0 -
N' NATIVEpr-GFP in SD

punctate,bud neck23.7929 -
N' TEF2pr-VC and Cyto-VN in SD

#N/A0 -
C’ GFP library in SD+DTT
punctate29.051.02No -
C’ GFP library in SD+H2O2

punctate30.941.09No -
C’ GFP library in Starvation Media
punctate22.490.79No -
C’ GFP library on the background of Pup2-DaMP

punctate -
C’ GFP library on the background of CCT mutant

punctate29.72361.04736No
